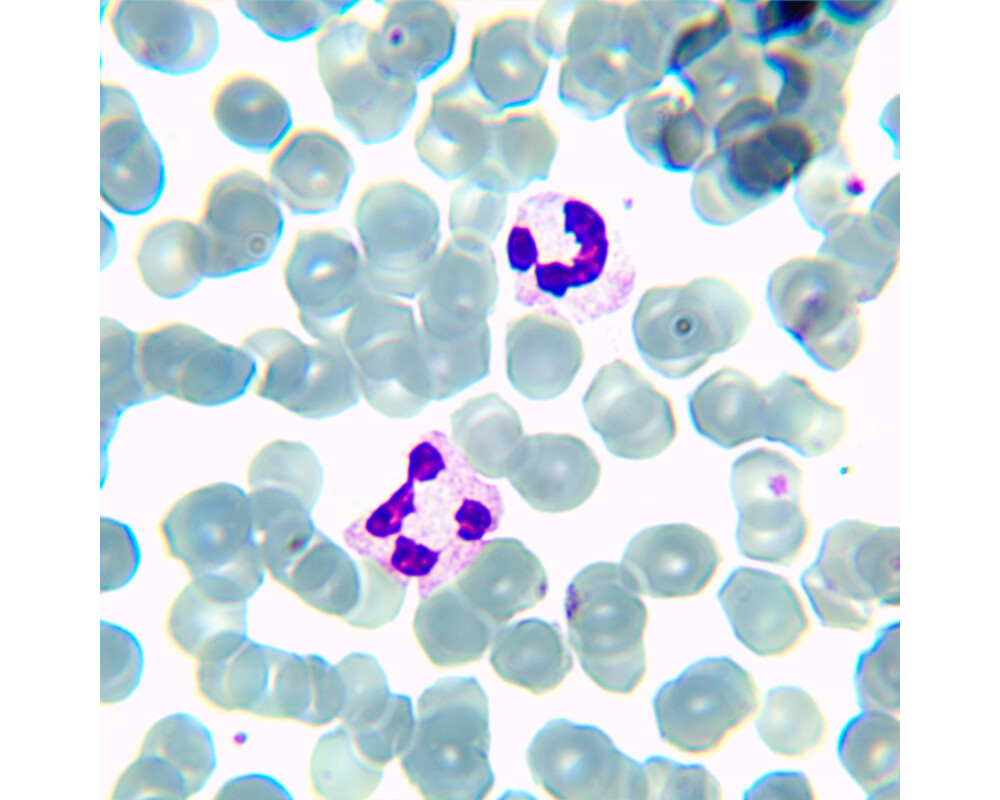

- Начало
- Оптични уреди и измервателни инструменти
- Микроскопи
- Magus
- Биологичен MAGUS Bio 230BL (ID: 686451)
Микроскоп Биологичен MAGUS Bio 230BL 82893
Плати по-лесно и сигурно с
ID: 686451
Характеристики
| Тип | биологичен, светлина/оптичен |
| Подходящо за | лабораторно/медицинско |
| Употреба | за професионалисти, опитни потребители |
| Монтаж и инсталиране | сложен |
| Technique | на светлото поле |
| Head | глава Gemel (Siedentopf, завъртане на 360°) |
| Head angle | 30 ° |
| Revolver | за 5 обектива |
| Увеличение, x | 40 — 1000 x |
| Окуляри | 10x/18 mm, разстояние от очите: 10 mm (*опция: 10х/20 mm със скала, 15x/11 mm, 16x/11 mm; 20x/11 mm) |
| Диаметър на окуляра | 23.2 мм. |
| Диоптрична корекция на окуляра | ±5 (на лявата тръба) |
| Фокусиране | коаксиален, грубо фокусиране (21 mm, 39,8 mm/кръг, със застопоряващ бутон и бутон за регулиране на затягането) и фино фокусиране (0,002 mm) |
| Diaphragm | диафрагма с регулируема апертура, полева диафрагма с регулируем ирис |
| Objectives | ахроматични с корекция до безкрайност: 4x/0,10; 10x/0,25; 40xs/0,65; 100xs/1,25 (масло); парфокално разстояние 45 mm (*опция: 20x/0,40; 60xs/0,80) |
| Филтри | да |
| Working distance | 18,89 (4x); 5,95 (10x); 0,775 (40xs); 0,36 (100xs); 2,61/8,80 (20x); 0,46 (60хs) mm |
| Разстояние между окулярите (IPD), mm | 48 — 75 мм. |
| Condenser |
кондензер Abbe
N.A. 1,25 с регулируем център регулируема височина диафрагма с регулируема апертура слот за плъзгач за метода на тъмното поле и плъзгач за фазовоконтрастно наблюдение монтировка тип „лястовича опашка“ |
| Light source type | светодиодно |
| Light source | светодиод 3 W |
| Light source placement | долно |
| Brightness control |
|
| Работна температура | 5 — 35 °С |
| Expansion | фазовоконтрастно устройство (кондензер и обективи), кондензер за метода на тъмното поле в имерсионно масло (сух или в масло), устройства за поляризация (поляризатор и анализатор) |
| Stage | 180x150 мм. |
| Stage adjustment | 75/50 |
| Stage features | двуосова механична предметна маса, без рейка за позициониране |
| Размери на продукта | 43x27x63 cm см. |
| Захранване | 220±22 V, 50 Hz, променливотокова мрежа |
| Тегло | 10 kg кг. |
| Гаранция | 24 месеца |
| Код на продукта | 82893 |
Виж повече
Допълнителна информация
<p>Magus Bio 230BL е бинокулярен микроскоп с ахроматични обективи и светодиодно осветление за наблюдение на биологични образци, като натривки и тънки разрези. Наблюденията се извършват по метода на микроскопията с преминаваща светлина (на светлото поле). Микроскопът може да бъде оборудван с допълнителни устройства за метода на тъмното поле, с поляризирана светлина и фазов контраст. Области на приложение: фармацевтика, медицина, биотехнологии, ветеринарна медицина, криминалистика, селско стопанство и др.</p>
<p><strong>Оптика</strong></p>
<p>Наблюдателните тръби могат да се завъртат на 360°, което Ви позволява да регулирате окулярите съобразно височината на наблюдаващия. На лявата тръба има пръстен за регулиране на диоптъра. В същата тръба може да се монтира цифров фотоапарат (купува се отделно).</p>
<p>Понеже револверната глава има 5 слота, освен доставените обективи може да се постави друг обектив, за да се постигне по-голямо увеличение във възможния диапазон на увеличение. Базовото увеличение на микроскопа е от 40 до 1000x, като горната граница може да бъде увеличена до 1500, 1600 или 2000x чрез добавяне на допълнителни окуляри. Оптичните елементи на микроскопа са коригирани до безкрайност. Револверната глава е ориентирана навътре.</p>
<p><strong>Осветление</strong></p>
<p>Източникът за преминаваща светлина е светодиод 3 W с променливотоково захранване. При регулирането на яркостта на осветлението цветната температура не се променя, а животът на светодиода е 50 000 часа.</p>
<p>Осветлението се контролира чрез регулиране на апертурата и полеви диафрагми, като има опция за поставяне на осветление на Кьолер. Кондензерът на Abbe може да се настройва по височина и да се центрира. Има опция за вкарване на плъзгач за метода на тъмното поле или за фазовоконтрастно наблюдение в слота на кондензера. Плъзгачът прави по-лесно превключването от един микроскопски метод към друг.</p>
<p><strong>Предметна маса и механизъм за фокусиране</strong> </p>
<p>Можете да местите обекта на изследването по предметната маса чрез механично приспособление, което може да се маха при необходимост. Предметната маса няма рейка за позициониране, при което механичната част заема по-малко място.</p>
<p>Фокусирането се управлява чрез бутоните за грубо и фино фокусиране. Тези бутони са на една и съща ос (коаксиални) от двете страни на микроскопа. Разположени в основата, те са удобни за завъртане с ръце без каквото и да било усилие. Грубото фокусиране има застопоряващ бутон и регулиране на затягането. Въртенето на бутона е плавно и лесно.</p>
<p><strong>Принадлежности</strong></p>
<p>Допълнителни принадлежности за микроскопа Magus Bio 230BL: кондензери за метода на тъмното поле, поляризиращи устройства, цифрови фотоапарати, калибрационни образци, окуляри, обективи, фазовоконтрастни устройства и др.</p>
<p><strong>Основни характеристики:</strong></p>
<ul>
<li>Ахроматични обективи с корекция до безкрайност, револверна глава с 5 слота</li>
<li>Бинокулярна глава с регулиране на диоптъра на лявата тръба</li>
<li>Регулиране на окуляра чрез завъртането му на 360°</li>
<li>Светодиодна крушка 3 W с живот 50 000 часа</li>
<li>Бутон и за грубо и фино фокусиране, бутон за регулиране на затягането при грубо фокусиране, бутон за застопоряване при грубо фокусиране</li>
<li>Полева диафрагма, опции за плъзгач за метода на тъмното поле и плъзгач за фазовоконтрастно наблюдение (монтирани в слота на кондензера)</li>
<li>Много допълнителни принадлежности</li>
</ul>
<p><strong>Комплектът включва:</strong></p>
<ul>
<li>Основа с вход за захранване, светлинен източник за преминаваща светлина, механизъм за фокусиране, предметна маса, кондензер и револверна глава</li>
<li>Бинокулярна глава </li>
<li>Ахроматичен обектив с корекция до безкрайност: 4x/0,1</li>
<li>Ахроматичен обектив с корекция до безкрайност: 10x/0,25</li>
<li>Ахроматичен обектив с корекция до безкрайност: 40x/0,65 (пружинно натоварен)</li>
<li>Ахроматичен обектив с корекция до безкрайност: 100x/1,25 (пружинно натоварен)</li>
<li>Окуляри 10x/18 mm с голямо разстоянието от очите (2 бр.)</li>
<li>Чашки на окулярите (2 бр.)</li>
<li>Филтри (4 бр.)</li>
<li>Бутилка с имерсионно масло</li>
<li>Шестостенен ключ</li>
<li>Променливотоково захранване</li>
<li>Покривало против прах</li>
<li>Ръководство за потребителя и гаранционна карта</li>
</ul>
<p><strong>Предлагат се по заявка:</strong></p>
<ul>
<li>Окуляр 15x/11 mm (2 бр.)</li>
<li>Окуляр 16x/11 mm (2 бр.)</li>
<li>Окуляр 20x/11 mm (2 бр.)</li>
<li>Ахроматичен обектив с корекция до безкрайност: 20x/0,4</li>
<li>Фазовоконтрастно устройство</li>
<li>Плъзгач за фазовоконтрастно наблюдение</li>
<li>Кондензер за тъмно поле NA 0,9</li>
<li>Кондензер за метода на тъмното поле в имерсионно масло NA 1,36–1,25</li>
<li>Плъзгач за метода на тъмното поле</li>
<li>Устройство за поляризация</li>
<li>Цифрова камера</li>
<li>Калибрационен образец</li>
</ul>
Виж повече
Допълнителна информация
Виж повече
Информация за производителя
| Контакт | [email protected] |
| Адрес | ул. Акад. Стефан Младенов 46, София, 1700, България |
| Уебсайт | https://magusmicro.bg/ |
Виж повече
Ние от PIC.bg постоянно полагаме усилия информацията на тази страница да е точна. В редки случаи съдържанието може да е некоректно. Всички снимки са с информативна цел и е възможно да съдържат аксесоари, които не са включени в стандартния пакет. Някои от спецификациите или цените могат да бъдат променяни от производителя без предизвестие или да съдържат експлоатационни грешки. Всички промоции, посочени в сайта, се предлагат до изчерпаване на количествата.
Отзиви
0.0
0 отзива.
5
0
4
0
3
0
2
0
1
0
Оцени продукта
Добави отзив